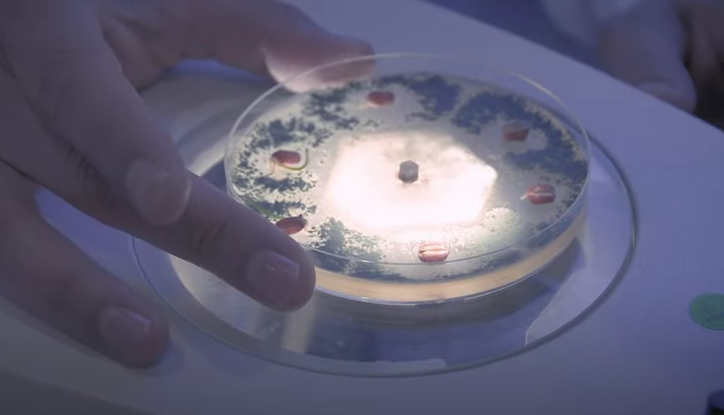
Biocontrol | Rizobacter

Biocontrol
Harnessing Nature's Power to Protect Your Crops
Rizobacter's biocontrol products offer a revolutionary approach to crop protection, harnessing the power of nature's own defenses to combat harmful pathogens and boost yields, all while preserving the environment.